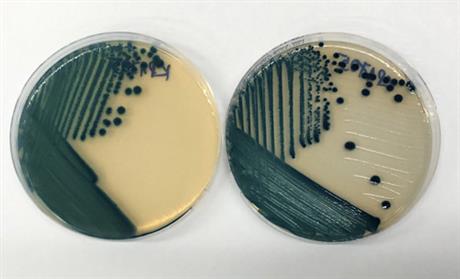
Chẩn đoán sớm nhiễm khuẩn bằng đĩa thạch ChromAgar CRE sản xuất trong nước

Techmart Công nghệ sinh học 2020: Công nghệ 5PRP kích thích lành hóa và tái tạo các mô tổn thương
Công nghệ 5PRP (huyết tương giàu tiểu cầu) với ưu điểm an toàn, hiệu quả điều trị cao, dễ sử dụng, sẽ được Viện Tế bào gốc (trường Đại học Khoa học Tự nhiên TP.HCM) giới thiệu tại Techmart Công nghệ sinh học 2020 do Trung tâm Thông tin và Thống kê KH&CN tổ chức vào các ngày 5-6/11 sắp tới.